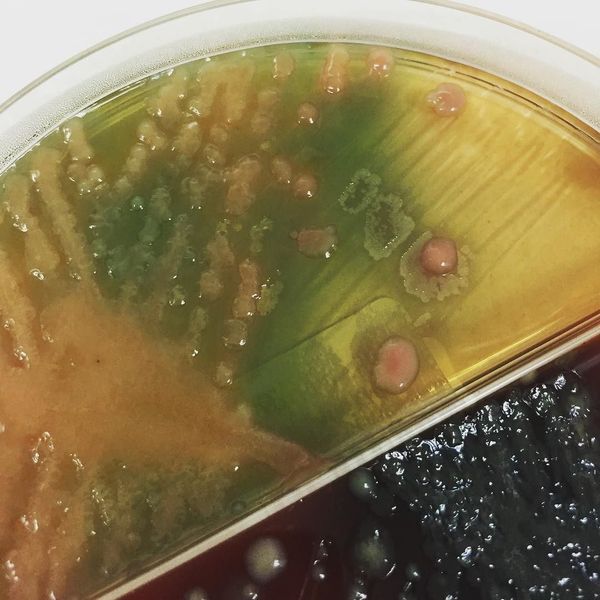
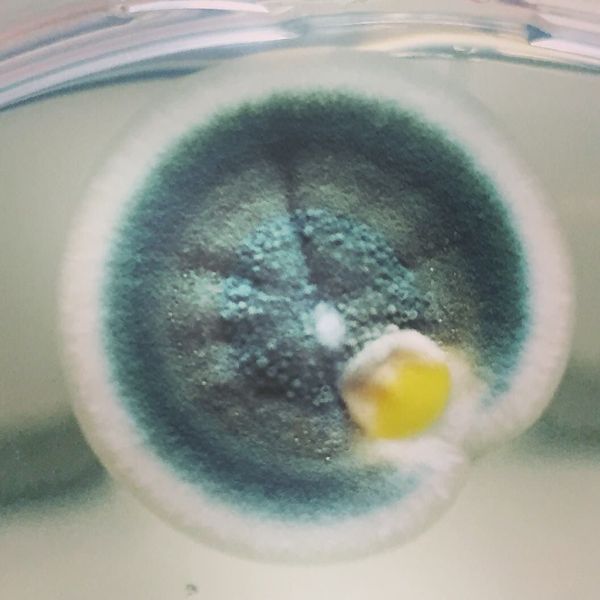
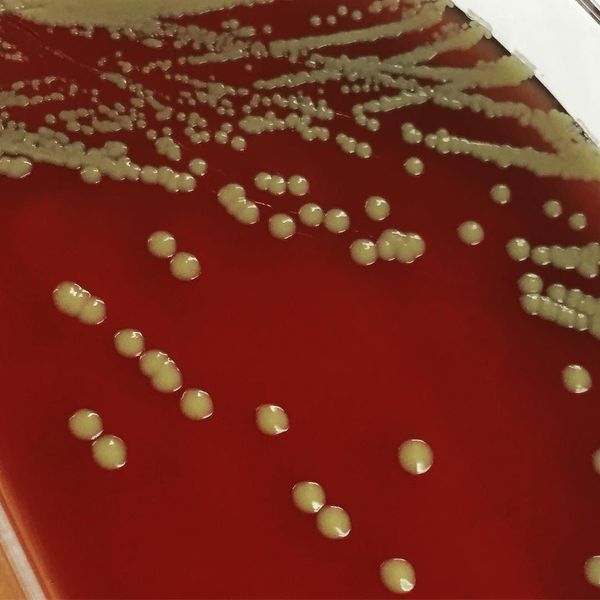
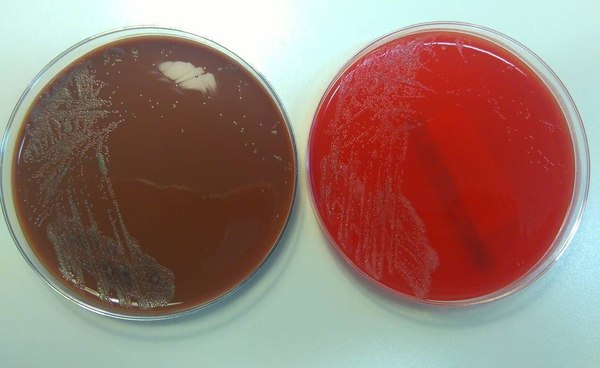
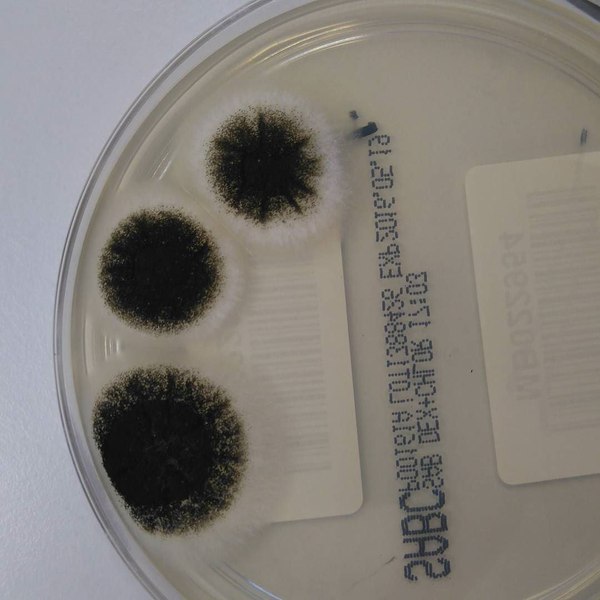
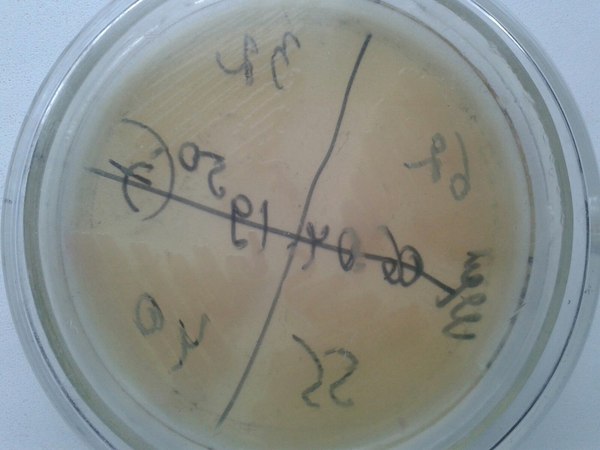
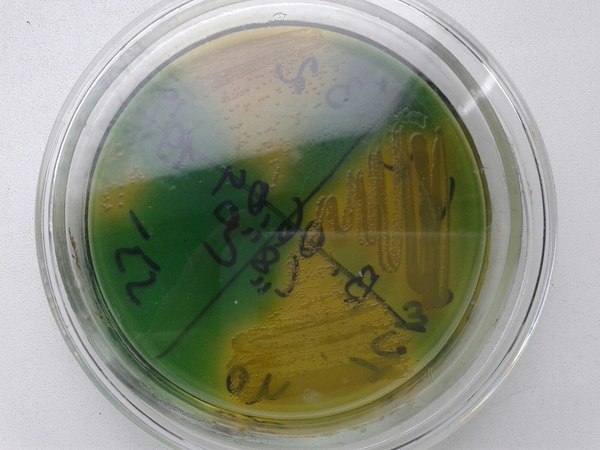
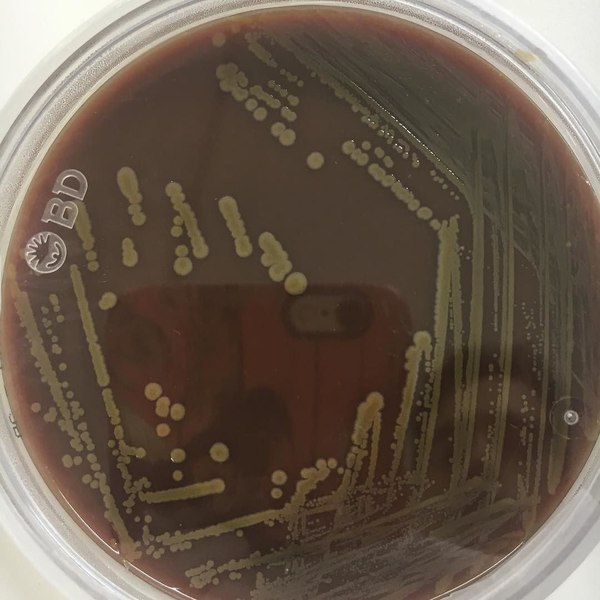
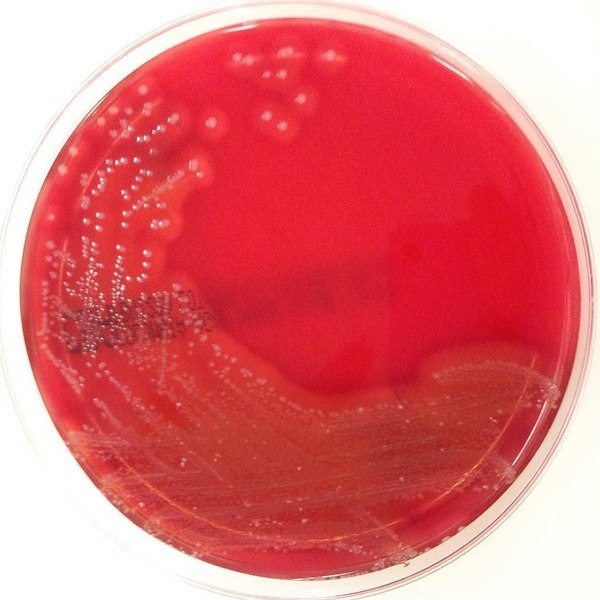
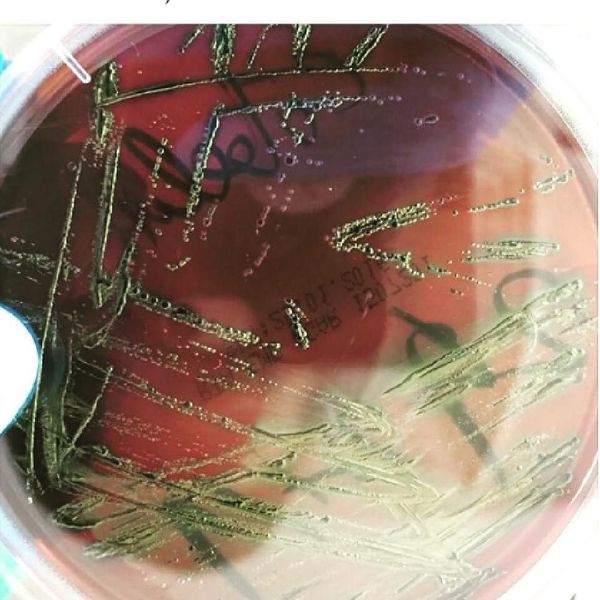

Физический парадокс, который никто не замечал но Максим Колесников ВСЁ исправил...
Всё, что мы знаем из классической физики, говорит нам, что движение тела можно рассчитать, опираясь на массу, скорость и внешние силы. Однако что, если мы скажем, что эти расчёты ошибочны, потому что не учитывают реальное влияние среды?
Мы провели простой эксперимент: взяли массивный объект и попытались передвинуть его на небольшое расстояние под водой. Согласно привычным школьным вычислениям, на это должно было уйти меньше 1 кДж энергии. Но реальный расчёт, учитывающий влияние воды, показал, что потребуется более 7.5 кДж!
🔬 Формула Максима Колесникова:
E=mc2⋅ k среда
Эта формула корректирует классическое уравнение Эйнштейна, включая коэффициент среды k_среда который учитывает плотность, давление и вязкость.
Formula for mass-energy correction due to environmental influence:
E = mc² * k_env ± (0),
Where:
k_env = (0.8 * ρ) / (0.5 * P + 0.2 * η)
✔ k env dynamically modifies mass-energy interactions based on density ρ, pressure P, and viscosity η.
✔ Environmental conditions directly affect physical properties of an object, making mass variable depending on the medium.
✔ This equation integrates spatial resistance effects, acoustic transmission constraints, and material compression factors into the mass-energy framework.
Summary application:
✔ Energy cannot be considered absolute in variable environments.
✔ Mass is dynamically altered by density and pressure fields.
✔ Future physics models must incorporate spatial-mass relations to refine fundamental equations.
💡 Главный вывод: Классическая физика строит расчёты, исходя из условий вакуума, а значит, не учитывает среду. В школе нам дают уравнения, которые работают только в идеализированном мире, но реальность гораздо сложнее!
Почему это важно?
✔ Автомобиль в воздухе и под водой требует разного количества энергии для движения.
✔ Но если следовать классическим уравнениям, разницы быть не должно!
✔ Реальный мир работает иначе – среда активно влияет на процессы, но это не учитывается в базовой физике.
Что это меняет?
Мы показали, что среда – это не просто внешний фактор, а активный участник любого движения. Любая инженерная система – корабли, подводные лодки, самолёты – уже учитывает влияние среды, но в фундаментальной физике всё ещё применяются устаревшие модели.
Почему? Потому что так удобнее, чем перестраивать всё научное мировоззрение.
Наш эксперимент показывает, что это не просто теоретический вопрос, а физическая реальность, которую игнорируют.
Пора обсудить!
Стоит ли пересматривать механические уравнения? Нужны ли корректировки в школьной физике? Как учитывать влияние среды в точных расчётах?
🔥 Мы ждем вашу реакцию! Давайте разберёмся, насколько точны наши знания о физике!